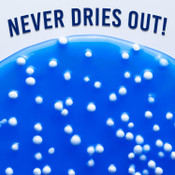
Crazy Aaron's Crackle'n Kracken Popp'n Thinking Putty Crazy Aaron's Crackle'n Kracken Popp'n Thinking Putty

Crazy Aaron's Rainbow Reveal Thinking Putty
Flat fee shipping. Excludes bulky items
My Wishlist
Share
Clear all
Love it? Add To My Wishlist
My wishlist allows you to keep track of all of your favourites and shopping activity whether you're on your computer, phone or tablet. You won't have to waste time searching all over again for that item you loved on your phone the other day - it's all here in one place!
Hello world!
Hello world!
Hello world!
Link successfully copied!
Please contact the store to confirm stock availability near you.
Please contact the store to confirm stock availability near you.
Regular and Pre-Order items cannot be purchased in the same transaction. Either remove the pre-order item(s) from the basket or purchase separately.











































![]()
![]()
![]()
Your cart is empty


The list of states available for shipping can be seen below.

Please contact the store to confirm stock availability near you.
Please contact the store to confirm stock availability near you.
Regular and Pre-Order items cannot be purchased in the same transaction. Either remove the pre-order item(s) from the basket or purchase separately.
We are currently delivering in NSW to Greater Sydney, Central Coast, South Coast and Newcastle as well as Brisbane, Gold Coast, Melbourne, Adelaide, Canberra and Perth. To check if we are delivering to you please add your postcode at checkout.
Shipping costs are flat fee, based on your location, for most items. All shipping costs can be calculated by adding your chosen products to your shopping cart then entering your postcode at checkout.
This excludes bulky items which have individual shipping costs. These items will be clearly marked as bulky on the product page. Some products will ship from different locations so you may receive multiple tracking notices.

Flat fee shipping. Excludes bulky items
Regular and Pre-Order items cannot be purchased in the same transaction. Either remove the pre-order item(s) from the basket or purchase separately.

Flat fee shipping. Excludes bulky items
Regular and Pre-Order items cannot be purchased in the same transaction. Either remove the pre-order item(s) from the basket or purchase separately.

Flat fee shipping. Excludes bulky items
Regular and Pre-Order items cannot be purchased in the same transaction. Either remove the pre-order item(s) from the basket or purchase separately.

Flat fee shipping. Excludes bulky items
Regular and Pre-Order items cannot be purchased in the same transaction. Either remove the pre-order item(s) from the basket or purchase separately.
 See in-store availability
See in-store availability